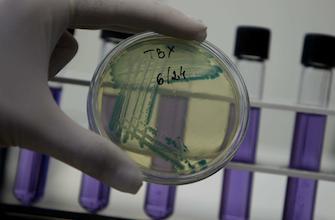

Publication dans Nature
Antibiotiques : comment les bactéries transmettent leur résistance
Une équipe britannique vient d’élucider le mécanisme par lequel les bactéries se transmettent leurs gènes de résistance aux antibiotiques.
- Par Afsané Sabouhi
- Commenting
- Oleg Popov/AP/SIPA
« Un véritable tour de force ! » En français dans le texte, c’est ainsi que le Pr Gabriel Waksman, chercheur de l’Institut de Biologie moléculaire et structurelle de Londres qualifie la découverte de son équipe, publiée dans la revue Nature. Ils viennent en effet d’élucider le mécanisme de sécrétion bactérienne de type IV, c’est à dire le mécanisme qui permet à une bactérie de sécréter vers sa voisine du matériel génétique.
Un mécanisme-clé de la résistance aux antibiotiques
C’est par ce biais que les bactéries sont notamment capables de se transmettre leurs gènes de résistance aux antibiotiques, d’où l’intérêt suscité par cette découverte. Par microscopie électronique, les chercheurs ont observé, sur le modèle bactérien Escherichia Coli, comment la bactérie constituait un canal dans ses membranes pour pouvoir sécréter vers l’extérieur une partie de son matériel génétique.
« Comprendre le système de sécrétion bactérienne pourrait aider à concevoir des composés capables de stopper le processus et ainsi d’interrompre la diffusion des gènes de résistance aux antibiotiques, explique le Pr Waksman. Les résistances aux antibiotiques sont si répandues qu’elles représentent une grave menace pour la santé humaine. Ces résultats pourraient donc avoir un impact considérable pour de futures recherches dans le domaine des antimicrobiens. » A l'échelle de l'Union Européenne, les résistances bactériennes aux antibiotiques coûtent chaque année 25 000 vies de malades victimes d'infections et 1,5 milliards d'euros, selon les estimations du Centre européen pour la prévention et le contrôle des maladies. Les bactéries sécrètent aussi des toxines infectieuses Par ce mécanisme de sécrétion aujourd’hui élucidé, certaines bactéries sont également capables de transmettre des toxines responsables d’infections. C’est le cas notamment d’Helicobacter Pylori, à l’origine des ulcères de l’estomac, de la bactérie responsable de la coqueluche et d’une légionelle pouvant transmettre des formes sévères de pneumonies. Comprendre par quel moyen les bactéries s’échangent ces toxines ouvrent également des perspectives pour comprendre et interrompre le mécanisme par lequel elles les transmettent à nos cellules humaines.























